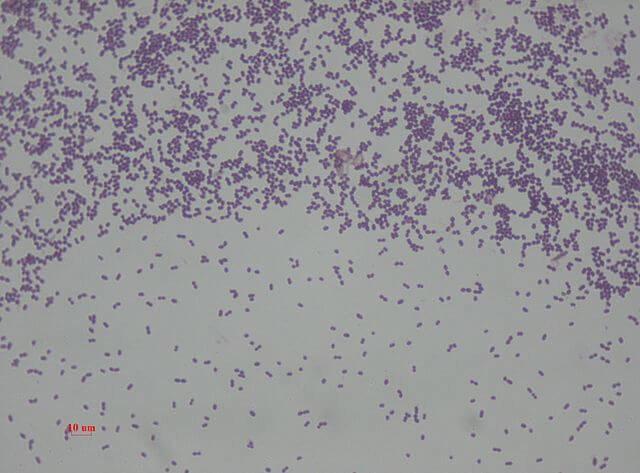
<p><strong><mark data-color="rgba(0, 0, 0, 0)" style="background-color: rgba(0, 0, 0, 0); color: inherit;">Gram-positive, facultatively anaerobic cocci found in the human intestine</mark></strong><span>. They are leading causes of nosocomial (hospital-acquired) infections, particularly urinary tract infections (UTIs)</span></p>

lab 13- bacterial pathogens : gram positive cocci, genus staphylococcus
1/15
There's no tags or description
Looks like no tags are added yet.
Name | Mastery | Learn | Test | Matching | Spaced | Call with Kai |
|---|
No analytics yet
Send a link to your students to track their progress
16 Terms
Staphyloccoci
divide in more than one plane to produce the streptococcus cell arrangement.

Streptococci and Enterococci
Gram-positive, facultatively anaerobic cocci found in the human intestine. They are leading causes of nosocomial (hospital-acquired) infections, particularly urinary tract infections (UTIs)
Staphylococci, Streptococci and Enterococci
bacteria genera which include species that are commonly found on epithelial surfaces such as skin and mucous membranes and are often cultured from patient samples during the process of disease diagnosis.
Pyogenic(pus forming)
gram positive cocci
Staphylococcus aureus
most common pathogen, commonly isolated from nasal passages.
Staphylococcus epidermidis
less pathogenic, capable of causing disease in humans and frequently the cause of nosocomial infections.
Nosocomial infections
infections resulting from hospital stays and were not present at the time of admission
hemolysis test
uses sheep blood agar plates (BAP) as the test medium and pure cultures are streaked across the surface. allows for the differentiation of different types of hemolysis.
hemolysins
hemolysis results from the presence of bacterial exotoxins

beta hemolysis
the complete destruction of erythrocytes and hemoglobin. If bacteria exhibit beta hemolysis, the normally opaque agar appears clear in the area immediately surrounding the growth.
Gamma hemolysis
non hemolysis, no change to the color of the blood agar.
coagulase test
differentiates Staphylococcus aureus (positive) from less pathogenic coagulase-negative staphylococci (CONS) by detecting the enzyme coagulase, which clots plasma. incubate at 35C

Selective agar
enhance growth for target organisms while inhibiting others using antibiotics, dyes, or salts
Differential agar
distinguish between microorganisms by causing visible changes (e.g., color) in colonies based on metabolic activity.
MSA test (mannitol salt agar)- selective
salt, concentration 7.5% NaCl which inhibits some bacteria. The agar is first examined for the presence or absence of growth. If growth is present, the test bacterium is tolerant
MSA test - differential
Mannitol, fermentable sugar and the pH indicator phenol red. Mannitol fermenters yellow - postive. red negative